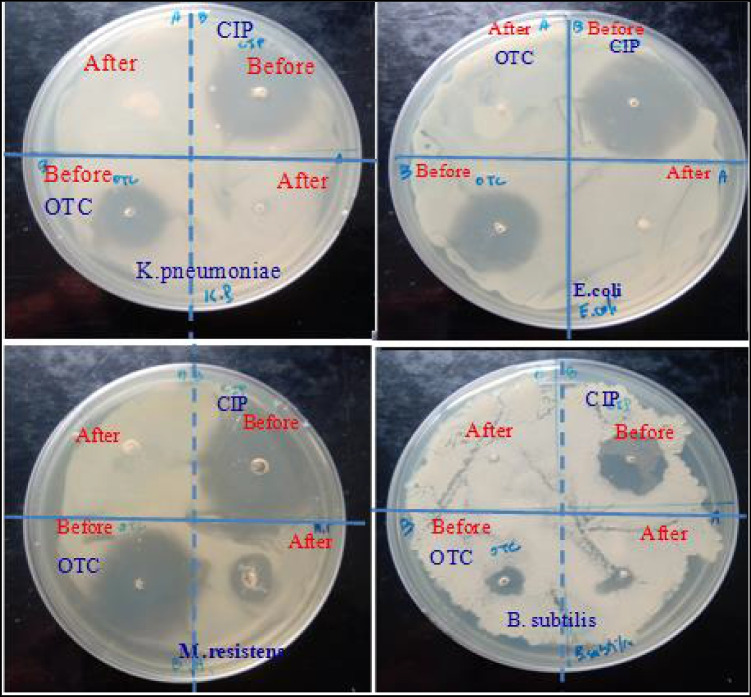

Abstract
Water contamination by multiple pollutants is a serious environmental issue originating from the many diverse sources of pollution. It has worsened with the appearance of new contaminants, named emerging micropollutants, such as drug residues which are considered a potential threat to human health and/or ecosystems. These require prior treatment before release into the environment. Simultaneous adsorption and photocatalysis as well as solid-liquid separation are promising technologies for water treatment. In order to obtain low cost photoactive nanocomposites, porous and magnetic Fe3O4-hydroxyapatite (wFeHAp) nanocomposites were prepared by soft chemistry from the dissociation of natural phosphate into Ca2+ and H3PO4 precursors, further neutralized by ammonia in the presence of preformed Fe3O4 particles. The magnetic nanocomposites were characterized and examined as effective antibacterial agents. Fe3O4 association with apatite modifies the surface properties of the wFeHAp nanocomposite materials, yielding efficient antimicrobial activity for S. aureus, B. subtilis, E. coli and K. pneumoniae strains. The photocatalytic removal of ciprofloxacin (CPF) and oxytetracyclin (OXT) antibiotics in water was also evaluated. The wFeHAp nanocomposites adsorbed and degraded the selected antibiotics successfully. Toxicity evaluation of the treated water after photodegradation using the four strains demonstrates the absence of toxic by-products at the end of the reaction. Therefore, Fe3O4@HAp nanoparticles are valuable for antimicrobial and photocatalysis applications.
Keywords: Fe3O4, Hydroxyapatite, Magnetic nanocomposites, Photocatalysis, Microbial activity
Introduction
Wastewater is a mixture of several water sources from domestic, industrial, commercial, and agricultural activities, which may contain many organic and mineral pollutants and makes it a complex medium. The toxicity and carcinogenicity of some contaminants discharged from industrial effluents creates serious environmental problems. Among them, the antibiotics used in human and animal therapy reach the environment through several routes, namely urine and excreta as well as expired products that were not carefully processed. Once released into the environment, antibiotic residues may have negative effects on biota at various trophic levels and on human health through the consumption of contaminated food and water. This promotes increased resistance of the bacteria in various environments.
Remediation techniques depend largely of the formulation of the antibiotic to be eliminated. Among these, adsorption and photocatalytic degradation are the subject of intense research and developments. All the various adsorbent/catalysts materials that were proposed have advantages and disadvantages. Magnetic nanoparticles such as iron oxide find many applications in various fields, such as magnetically assisted drug delivery [1], electrochemical sensors [2, 3], magnetic separation solid/liquid [4], and catalysis [5, 6]. However, these nanoparticles also exhibit some drawbacks, such as poor stability and aggregation. Their association with porous solid provides an efficient route to prevent their aggregation in liquids and improve their chemical stability. Among the iron oxides, the three most studied polymorphs are magnetite (Fe3O4) of inverse spinel structure, maghemite (γ-Fe2O3) of derived spinel structure, and hematite (α-Fe2O3) of hexagonal structure. Fe3O4 nanoparticles can be easily synthesized and functionalized and retain their magnetic properties for the easy separation from water after remediation. They were successfully associated within numerous matrices such as polymer [7], graphene oxide [8], silica [9–11], bentonite/ZnO [12], TiO2 [4, 13] and SiO2/CeO2 core-shell magnetic nanoparticles [14]. Hydroxyapatite (HAp) Ca10(PO4)6(OH)2 finds applications in medicine as a bone material, as well as binder for many organic and inorganic pollutants [15–17]. Fe3O4/hydroxyapatite composites were also developed for medical applications [18–20], and for dye photodegradation [21–23]. To our knowledge, these nanocomposites were prepared from commercial calcium and phosphate precursors, which are relatively expensive on an industrial scale [24]. In our previous study was used rock phosphate ore as a natural precursor to grow porous hydroxyapatite by dissolution followed by precipitation. ZnO-HAp and TiO2-HAp nanocomposites were developed through this method for environmental applications. To avoid filtration and recycle suspended powders with a magnetic field after each water treatment, magnetic Fe3O4 nanoparticles were combined with hydroxyapatite (HAp) prepared from rock phosphate by dissolution/precipitation yielding recyclable Fe3O4-HAp composite nanoparticles for photocatalysis.
The physical and chemical properties of magnetic nanoparticles largely depend on the mode of synthesis. A simple and specific method was been developed to get paramagnetic nanoparticles. The converted apatite material was combined with magnetic Fe3O4 nanoparticles. The resulting magnetic composite nanoparticles were tested for the degradation of ciprofloxacin (CPF) and oxytetracyclin (OXT) residues chosen as a model drug pollutant in water. The magnetic properties of Fe3O4-HAp can provide a suitable way to separate suspended powder from the reaction mixture using an external permanent magnet.
Experimental
Preparation and characterization of theFe3O4-HAp nanocomposites
The most widely used method to obtain highly dispersed magnetic Fe3O4-HAp nanoparticles in HAp matrix with significant adsorption and catalytic activities is to introduce the previously Fe3O4 prepared particles in the aqueous solution containing Ca2+ and PO43− ions dissolved from natural phosphate. Co-precipitation is an easy and convenient method to synthesize Fe3O4 from aqueous Fe2+ and Fe3+ salt solutions by the addition of ammonia at pH 10 under inert atmosphere at room temperature to control its magnetic properties. Consequently, the resulting ultrafine magnetic particles are magnetically separated using an external permanent magnet and washed several times with distilled water and dried in an oven at 100 °C overnight. As described in our previous work [25], the pure hydroxyapatite was prepared from phosphate rock by dissolution in nitric acid solution to obtain Ca2+ and H3PO4 species, and reprecipitation by concentrated ammonia addition. Finally, the mixture is filtered and the precipitate is washed with deionized water and dried overnight at 100 °C. For Fe3O4-HAp nanocomposites, the Fe3O4 is added to the (Ca2+ and H3PO4) solution dissolved from natural phosphate and then addition of a concentrated ammonia solution (25%) at adjusted pH = 10 and at room temperature (Fig. 1).
Fig. 1.
Experimental scheme of the preparation of magnetic wFeHAp powders
As realized in the Fe3O4 case, the magnetic nanoparticles were separated from aqueous mixture by an external permanent magnet. The amount of added Fe3O4 content was varied to obtain a theoretical final Fe3O4:HAp weight ratio w = 10, 20 and 30wt.%, and the resulting composite materials were called wFeHAp. The powders were dried at 100 °C for 24 h and calcinated at 500 °C for 3 h. Solid-liquid separation and filtrate recovery were performed using an external magnet as shown in Fig. 2.
Fig. 2.
Solid-liquid separation and filtration recovery using wFeHAp nanoparticles under external magnet
Photocatalytic activity
The photocatalytic efficiencies of wFeHAp nanopowders heated at 500 °C were evaluated under UV-light irradiation (Lamp HPK 125 W UV light A-B-C (200–600 nm) using a homemade Pyrex helical photoreactor of 250 mL. The source of irradiation was placed in the center of the reactor to insure the maximum energy exchange between the source of the irradiation and the reaction mixture that flows out continuously. Two tubular compartments surrounding the lamp were used for cooling. 200 mg of wFeHAp catalyst was preliminary dispersed in 100 mL of a 20 mg L− 1 antibiotic solution at pH close to 6, and left for 30 min stirring in the dark and was then exposed to ultraviolet light. At each selected time, samples were taken and centrifuged and the supernatants were stored in the dark for analysis. The instantaneous residual antibiotic concentration in the supernatant (in mg/L) was monitored using a UV-Visible spectrophotometer (PerkinElmer Lambda II) at 273 nm for CPF and 354 nm for OXT. Some characteristics of the two antibiotics are given in Table 1.
Table 1.
Chemical structure and physico-chemical parameters for CPF and OXT antibiotics
| Antibiotic | Formula | Molar mass (g/mol) | Solubility (g/L) | pKa | λmax (nm) |
|---|---|---|---|---|---|
| CPF |
|
331.35 | 30 | 6.10; 8.7 | 273 |
| OXT |
|
460.4 | 0.314 g/L | 3.3; 7.3; 9.1 | 354 |
Antibacterial experiments
The agar well diffusion method was used to evaluate the antimicrobial activity of wFeHAp magnetic powders compared with those of individual HAp and Fe3O4 materials. Similar to the disk diffusion procedure, the surface of the Mueller Hinton agar plate is inoculated by spreading a volume of the microbial inoculum over the entire surface of the agar (20–100 µl) depending on the growth of each strain. Then, 6–8 mm diameter hole is drilled aseptically with a sterile tip, and a volume of 10 µL of the antimicrobial agent is introduced into the well. The media used in this test was Mueller Hinton agar plate (Beef extract 2 g, acid hydrolysate of Casein 17.5 g, Starch 1.5 g, and an amount of agar 17 g/l). The antimicrobial agents diffuse in Mueller Hinton agar medium and inhibition zone size was measured in millimeters, and the assay was performed in triplicate, while the control Tetracycline (TET) (30 µg) disks (Sigma) were used as a reference antibiotic. The compounds were diluted with DMSO (1%) and their concentrations were adjusted to 1 mg/ml. According to the growth of each strain, 20 to 100 µl of an overnight grown culture (turbidity of 0.5 to 0.8) were spread onto Petri dish plates. All materials were steam-sterilized at 120 °C for 20 min. A 20 ml sterile culture medium was inoculated with Gram-positive bacteria Staphylococcus aureus ATCC 12,600, Microbacterium resistants (MW471633), Bacillus subtilis (MW471619) and Gram-negative bacteria, Escherichia coli ATCC 11,775, Klebsiella pneumoniae (MW524112), and Pseudomonas chloritidismutans (MW559720).
Results and discussions
Characterization of the wFeHAp powders
After drying the powders at 100 °C, the main diffraction lines are indexed as being reflections of the typical planes of the poorly crystallized apatitic phase (002), (211), (112) and (200) corresponding respectively to the diffraction angles at 2θ = 26°, 31°, 32°, 34° (JCPDS 09-0432) (Fig. 3). For the as-synthesized Fe3O4, it shows main characteristic diffraction peaks at 30°, 35°, 43° with a face-centered-cubic structure (JCPDS card No. 65-3107). The addition of Fe3O4 nanoparticles to the filtrate resulting from the dissolution of natural phosphate affects the crystallinity of HAp and forms wFeHAp nanocrystallites. Note that the incorporation of different Fe3O4 contents does not lead to any alteration of the HAp structure and no peaks corresponding to the secondary phases are detected such as iron phosphates showing the adequate purity of the Fe3O4-HAp composites. With the exception of poor crystallinity of the 10FeHAp, the diffraction lines of Fe3O4 appear and intensify when the content of the latter increases in the composite. The poorly crystalline of 10FeHAp phase in the may reflect good chemical bonding between hydroxyapatite and iron oxide.
Fig. 3.
X-ray diffractograms of the wFeHAp composite powders compared to pure HAp and Fe3O4 a dried at 100 °C and b calcined at 500 °C
Heat treatment of wFeHAp composites at 500 °C for 3 h slightly improves their crystalline structures by keeping the Fe3O4 phase associated with the apatite structure, but more intensely in the 30FeHAp case. However, the calcination of the Fe3O4 powder at 500 °C modifies its structure and reveals a new phase attributed to α-Fe2O3, demonstrating that there was an oxidation reaction of Fe2+ ions to Fe3+ in the absence of apatite nanoparticles. Thus, the presence of apatite in wFeHAp composites blocks the oxidation reaction of Fe2+ ions by stabilizing them. Another time, no secondary phase such as iron phosphates could be detected whatever the Fe3O4 content associated with apatite, which confirms that these systems are stable at 500 °C. At this temperature, the magnetic character is preserved under external magnet serving for a solid-liquid separation. Raising the calcination temperature above 500 °C leads to the loss of magnetism and therefore falls outside the scope of this study.
With constant calcium and phosphorus contents in the phosphate rock used, the addition of Fe3O4 suspensions affects the Ca/P molar ratio of the wFeHAp precipitates. This ratio decreases from 1.89 for HAp to 1.70 for 30FeHAp demonstrating that the presence of magnetic Fe3O4 nanoparticles has an influence on the formation of apatite.
In order to perceive the influence of the association of Fe3O4 on the porosity of the hydroxyapatite HAp, the N2-sorption isotherms using the BET method and the distribution of the pores on the surface of the composites according to the BJH method were carried out. The isotherms obtained are characterized by a gradual increase in the quantity of N2 adsorbed as a function of the relative pressure P/P0 having a type IV hysteresis loop according to the IUPAC classification, which indicates that the wFeHAp composites have a mesoporous texture. In the Fe3O4 case, its adsorption/desorption hysteresis is less clear reflecting a porosity different from that of HAp or those of wFeHAp.
After drying at 100 °C, wFeHAp composites exhibit SBET values between 150 m2g− 1and 180 m2/g, depending on the Fe3O4 content, but overall around that of pure HAp, which are higher than that of pure HAp (165 m2g− 1), but an order of magnitude larger pour Fe3O4 (32 m2g− 1). This strongly suggests that the wFeHAp particles obtained are better divided and uniformly dispersed, revealing, in fact, that the association of magnetic Fe3O4 particles with hydroxyapatite improves the specific surface of the composites formed. The average Dp pore size of HAp and Fe3O4 is 4 and 14 nm respectively, while wFeHAp composites have two crystallite populations around 5 and 11 corresponding to the association of Fe3O4 with HAp. Thus, this surface modification could offer interesting adsorption and photodegradation activities as well as a good solid/liquid separation thanks to the preservation of the Fe3O4 magnetism in the composites. After heat treatment at 500 °C, SBET values decreased slightly due to two antagonistic factors: grain growth and pore release by degradation or evaporation of some residues.
Surface characterization and control of sorption mechanisms at solid-liquid interfaces are of primary importance. Note that the efficiency and control of the sorption and photocatalysis mechanisms are necessary in the retention of harmful substances.
The specific surface of the powders was determined from N2 sorption measurements and the application of the BET method (Fig. 4). After drying at 100 °C, the wFeHAp powders show SBET values between 150 and 180 m2g− 1, depending on the Fe3O4 content impregnated in the HAp matrix. These values are of the order of that of pure HAp (165 m2g− 1) and an order of magnitude higher than that of Fe3O4 alone (32 m2g− 1) (Table 2). This suggests that both types of particles, Fe3O4 and HAp, are more evenly dispersed in the resulting wFeHAp composite. Heat treatment of powders at 500 °C reduces SBET values, but less dramatically than at elevated temperatures. Note that the choice of this temperature was considered based on the recycling process of these powders taken as catalysts for the degradation of selected antibiotics. The average pore size Dp is between 12 and 13 nm for dried wFeHAp samples, slightly less than 14 nm for HAp and significantly larger for Fe3O4 (5 nm).
Fig. 4.

N2-sorption curves of the wFeHAp composite powders compared to pure HAp and Fe3O4 dried at 100 °C
Table 2.
Chemical composition (Ca/P and Fe/Ca), Specific surface (SBET), and average pore size Dp of the wFeHAp composite materials compared to those of HAp and Fe3O4.
| Ca/P Molar ratio |
Fe/Ca | SBET100 (m2g− 1) |
Dp100 (nm) |
SBET500 (m2g− 1) |
Dp500 (nm) |
|
|---|---|---|---|---|---|---|
| NP | 1.95 | - | 20 | 4 and 14 | 11 | 4 and 13 |
| HAp | 1.89 | - | 165 | 14 | 105 | 12 |
| 10FeHAp | 1.88 | 0.11 | 180 | 5; 13 | 150 | 4; 12 |
| 20FeHAp | 1.76 | 0.24 | 170 | 5; 13 | 140 | 4; 11 |
| 30FeHAp | 1.70 | 0.37 | 150 | 5; 12 | 120 | 4, 11 |
| Fe3O4 | - | - | 32 | 5 | 22.5 | 4 |
TEM imaging of supports of 30FeHAp, HAp, Fe3O4 calcined at 500 °C shows aggregates of particles approx. 10–30 nm in length, some of them incorporating electrons dense nanoparticles of 5 to 8 nm (Fig. 5). These nanoparticles are significantly more abundant in the 30FeHAp sample compared to the HAp powder, suggesting that they correspond to a phase rich in iron oxide. Based on the XRD data, these can therefore be attributed to unhindered Fe3O4 nanocrystals in the HAp matrix; this suggests that the presence of hydroxyapatite limits the growth of Fe3O4 nanoparticles within the Fe3O4-HAp composite.
Fig. 5.
TEM images of 30FeHAp (a), b HAp and c Fe3O4 calcined at 500 °C
Antibacterial assay
The zone of inhibition of powders against bacteria is shown in Fig. 6. Compared to individual HAp, Fe3O4 powders, and Tetracyclin (as control), the magnetic powders have considerable inhibitory effect on all assayed bacteria strains except Microbacterium resistants and Pseudomonas chloritidismutans.
Fig. 6.
Antibacterial activities of wFeHAp nanoparticles compared to tetracycline antibiotic as reference and individual Fe3O4 and HAp powders
The highest zone of inhibition is observed in Bacillus subtilis bacteria supported on 20FeHAp. This demonstrates that Fe3O4 association with apatite affects the surface properties of formed wFeHAp nanocomposite materials with good antimicrobial activity for strains, i.e. S. aureus, B. subtilis, E. coli and K. pneumoniae while they are less effective for M. resistants and P. chloritidismutans bacteria. Results showed that the antibacterial activities of wFeHAp magnetic powders are related to the chemical composition and surface of the material. Compared to the 30FeHAp nanocomposite, the advantage of the porosity of 20FeHAP can play a key parameter in the improvement of the antibacterial activity in particular against the S. Aureus (+), B. Subtilis (+) and K. Pneumoniae (-) bacteria. However, synergy between Fe content and porosity in the composite can occur for good antibacterial efficacy. There are numerous reasons to justify the present antibacterial tests. It is possible that these magnetic nanoparticles exert their antibacterial action by interactions of the simultaneous ferric and phosphate ions with proteins and DNA thus causing conformational changes in protein structure and DNA molecule, which ultimately leads to the death of bacteria cell. Similarly, the generation of reactive oxygen species (ROS) was also involved as mechanism of antibacterial action. Moreover, proteins can also be adsorbed on the surface of wFeHAp, which inactivates the bacteria tested. For pure hydroxyapatite, the antibacterial activity comes from the phosphate species, which can cause the uncoupling of respiratory electron transport from oxidative phosphorylation by inhibiting respiratory chain enzymes [26]. However, there was only the possibility of ferric ion-protein interactions for iron oxide.
Photodegradation activity
As we have previously recalled, the antibiotics CPF and OXT poses a serious environmental problem if no prior treatment is carried out. To remedy this, the Fig. 7 illustrates its photocatalytic kinetics supported on wFeHAp photocatalysts prepared from rock phosphate in the presence of Fe3O4 magnetic nanoparticles. The photocatalytic activity of wFeHAp nanoparticles was evaluated by following the degradation rate of the CPF and OXT drugs as a function of the Fe3O4 content associated with the HAp (Fig. 7). No degradation has been observed in the absence of the catalyst (photolysis) indicating that it was difficult for the degradation without catalyst suggesting that light alone is not an effective remediation. In the dark and with catalyst, there was only adsorption of the pollutant on the catalyst surface. When the lamp is turned on, the degradation activity started and became more efficient with increasing Fe3O4 content in the wFeHAp nanocomposites.
Fig. 7.
Kinetics of photodegradation of (a) CPF and b OXT by the wFeHAp composite powders heated at 500 °C compared to pure HAp and Fe3O4 during a first 30 min period in the dark following by UV-light. Initial antibiotic concentration C0 = 20 mg L− 1, catalyst dose 2 gL− 1, pH = 6, room temperature (24 °C)
For pure HAp, the adsorption step is predominant followed by a slight photodegradation as demonstrated in our previous work [27]. However, the best photocatalytic efficiency is found in the presence of 30FeHAp nanoparticles with a complete elimination of CPF and 98% for OXT after 6 h as illuminating time. The results showed that 30FeHAp being the best photocatalyst for effective destruction of drug residues in water according to the operating conditions used.
The degradation process can be related to the band gap values of wFeHAp close to that of Fe3O4 (3.9 eV), but far from HAp (5.5 eV). This low band gap of magnetic nanocomposites is a suitable candidate for use as a photocatalyst in the UV light. As shown in the Fig. 7, hydroxyapatite alone cannot degrade the drug, but Fe3O4 degrades it poorly, while wFeHAp nanoparticles are considered significant catalysts. Here is related to the physical and chemical properties of magnetic nanoparticles and largely depend on the synthesis method and chemical structure. Indeed, the addition of the Fe3O4 nanoparticles to the filtrate solution contained the Ca2+ and PO43− precursors from natural phosphate blocks the growth of the grains of hydroxyapatite favoring a good specific surface of the magnetic nanoparticles formed and inducing interactions between the oxide of iron and the surface of HAp. When wFeHAp is illuminated with UV light, the photo-induced electronic excitation will occur, which is transferred to the surrounding oxygen followed by the formation of •O2− radicals [28, 29]. The generated superoxide radical is a powerful oxidizing agent, which can not only oxidize antibiotic molecules, but also react with H2O molecules and OH− ions and produce •OH radicals which further oxidize molecules present on the surface of the wFeHAp nanoparticles [30].
To confirm the degradation and the formation of by-products less (or not) toxic than the parent molecules, the toxicity of the solutions before and after the photodegradation process of the CPF and OXT antibiotics was evaluated in the presence of 30FeHAp magnetic photocatalyst. Antimicrobial testing was performed using the agar disk diffusion method as previously described for the wFeHAp powders. Six bacterial strains were tested: Three Gram (+) bacteria (Staphylococcus aureus, Microbacterium resistants, Bacillus subtilis) and three Gram(-) bacteria, Escherichia coli, Klebsiella pneumoniae, and Pseudomonas chloritidismutans). Figure 8 shows the evolution of the diameter of the clear zone of the antibacterial test for the CPF and OXT solutions, before and after the photocatalytic reaction in the presence of 30FeHAp, against Gram-positive bacteria.
Fig. 8.
Evolution of the diameter of the clear zone of the antibacterial test for the CPF and OXT solutions, before and after the photocatalytic reaction in the presence of 30FeHAp.
The results indicate that the water released after CPF photodegradation supported on a 30FeHAp catalyst is generally non-toxic towards the tested strains, confirming the absence of toxic species of the parent antibiotic or the by-products formed. On the other hand, a less intense zone of inhibition is observed for the solution after the OXT degradation. This is attributed either to the residual antibiotic in small quantity or to a by-product. Therefore, these results are confirmed by HPLC spectra where no peak is observed for CPF degradation on 30FeHAp catalyst at the end of the photocalysis reaction for 6 h as lighting time, whereas a small peak was identified for OXT with a weight ratio of 3% under the same conditions.
Moreover, solid-liquid separation after the photodegradation reaction using a magnetic catalyst remains an efficient approach. The choice of a porous magnetic catalyst wFeHAp focused on the reactivity of the adsorption sites, which can enter into competition between the pollutant and the intermediate products during or at the end of the photocatalytic reaction. Several works evoke the by-products after the photocatalytic degradation reaction. With a TiO2/HAp and ZnO/HAp as porous catalysts, it has been demonstrated that there are no intermediate products at the end of the reaction [27, 31]. These seem to have adsorbed on the porous surface of the catalyst, which will then be recycled by a heat treatment at low temperature (500 °C). It appears that there is a correlation between the adsorption and the photocatalytic degradation of the CPF and OXT studied in the presence of wFeHAp catalysts. The differences in specific surface and in density of the hydroxyl groups on the catalyst surface are likely to be at the origin of the best photocatalytic activity associating the couple (e−, h+) under UV light.
After association of iron oxide with the HAp matrix, the photodegradation of polluting drugs improved as a function of the level of iron oxide. This modification significantly increased its specific surface and the concentration of hydroxyl groups. In a typical photocatalytic reaction, electrons and holes photogenerated upon excitation of the catalyst by photons of energy equal to or greater than its valence band energy (Eg) are gained by O2 and H2O adsorbed by the porous catalyst forming superactive oxidants •OH et O2•−. Thus, increasing the amount of hydroxyl not only increases the trapping sites for photo-induced h+, but can also increase the trapping sites for photo-induced electron by adsorbing more O2, resulting in more hydroxyl radicals to participate in the photocatalytic reaction. These •OH radicals formed have a strong oxidizing power and can lead to complete mineralization after several cycles of adsorption/photodegradation under the effect of porous catalyst and UV light.
Conclusion
Iron-oxide-hydroxyapatite magnetic nanocomposites prepared from natural phosphate by simultaneous dissolution/precipitation are efficient catalysts for the UV-photodegradation of CPF and OXT antibiotics in water. The high Fe3O4 content in the 30FeHAp nanocomposite improves photocatalysis compared to the individual HAp and Fe3O4 phases. This originates from the smaller size and better dispersion of the Fe3O4 nanoparticules. The two antibiotics have distinct degradation pathways owing to their affinity for the photocatalyst surface. In consequence, water decontamination on 30FeHAp benefits from multiple functions as adsorption, catalytic efficiency and separation.
Authors’ contributions
Equal.
Data availability
Not applicable.
Declarations
Ethics approval
Not applicable.
Consent for publication
Authors give their consent for publication.
Competing interests
On behalf of all authors, the corresponding author states that there is no conflict of interest.
Footnotes
Publisher’s note
Springer Nature remains neutral with regard to jurisdictional claims in published maps and institutional affiliations.
References
- 1.Patil GV. Biopolymer albumin for diagnosis and in drug delivery. Drug Dev Res. 2003;58:219–247. doi: 10.1002/ddr.10157. [DOI] [Google Scholar]
- 2.Yola ML, Göde C, Atar N. Determination of rutin by CoFe2O4 nanoparticles ionic liquid, nanocomposite as a voltammetric sensor. J Mol Liquid. 2017;246:350–3. doi: 10.1016/j.molliq.2017.09.072. [DOI] [Google Scholar]
- 3.Baghayeri M, Zare EN, Lakouraj MM. A simple hydrogen peroxide biosensor based on a novel electro-magnetic poly (p-phenylenediamine)@Fe3O4 nanocomposite. Biosens Bioelectron. 2014;55:259–265. doi: 10.1016/j.bios.2013.12.033. [DOI] [PubMed] [Google Scholar]
- 4.He HY, Lu J. Highly, photocatalytic activities of magnetically separable reduced graphene oxide-CoFe2O4 hybrid nanostructures in dye photodégradation. Sep Purif Technol. 2017;172:374–81. doi: 10.1016/j.seppur.2016.08.040. [DOI] [Google Scholar]
- 5.El Guerdaoui HR, Ouachtak A, El Haouti H, Bouddouch R, Hafid A, Bakiz N, Santos B, Taha DMF, Jada ML, Ait-Addi A. Design of direct Z-scheme superb magnetic nanocomposite photocatalyst Fe3O4/Ag3PO4@Sep for hazardous dye degradation. Sep Purif Technol. 2022;277:119399. doi: 10.1016/j.seppur.2021.119399. [DOI] [Google Scholar]
- 6.Ortiz-Quiñonez JL, Díaz D, Zumeta-Dubé I, Arriola-Santamaría H, Betancourt I, Santiago-Jacinto P, Nava-Etzana N. Easy synthesis of high-purity BiFeO3 nanoparticles: new insights derived from the structural, optical, and magnetic characterization. Inorg Chem. 2013;52:10306–10317. doi: 10.1021/ic400627c. [DOI] [PubMed] [Google Scholar]
- 7.Shin S, Yoon H, Jang J. Polymer-encapsulated iron oxide nanoparticles as highly efficient Fenton catalysts. Catal Commun. 2008;10:178–182. doi: 10.1016/j.catcom.2008.08. [DOI] [Google Scholar]
- 8.Rosari S, Ardiansyah T. Degradation of methylene blue and congo-red dyes using Fenton, photo-Fenton, sono-Fenton, and sonophoto-Fenton methods in the presence of iron(II,III) oxide/zinc oxide/graphene (Fe3O4/ZnO/graphene) composites. Sep Purif Technol. 2019;210:563–73. doi: 10.1016/j.seppur.2018.08.030. [DOI] [Google Scholar]
- 9.Zhang H, He Q, Zhao W, Guo F, Han L, Wang W. Superior dyes removal by a recyclable magnetic silicate@Fe3O4 adsorbent synthesized from abundant natural mixed clay. Chem Eng Res Design. 2021;175:272–82. doi: 10.1016/j.cherd.2021.09.017. [DOI] [Google Scholar]
- 10.Rehman GU, Tahir M, Goh PS, Ismail AF, Hafeez A, Khan IU. Enhancing the photodegradation of phenol using Fe3O4/SiO2 binary nanocomposite mediated by silane agent. J Phys Chem Solids. 2021;153:110022. doi: 10.1016/j.jpcs.2021.110022. [DOI] [Google Scholar]
- 11.Zhang C, Si S, Yang Z. Facile synthesis of Fe3O4/SiO2/molecularly imprinted hydroxyapatite nanocomposite and its enhanced photocatalytic degradation of target contaminant. Sep Purif Technol. 2015;143:88–93. doi: 10.1016/j.seppur.2015.01.030. [DOI] [Google Scholar]
- 12.Rahimi SM, Panahi AH, Mazari NS, Allahyari E, Nasseh N. Breaking down of low-biodegradation Acid Red 206 dye using bentonite/Fe3O4/ZnO magnetic nanocomposite as a novel photo-catalyst in presence of UV light. Chem Phys Lett. 2022;794:139480. doi: 10.1016/j.cplett.2022.139480. [DOI] [Google Scholar]
- 13.Gnanasekaran L, Hemamalini R, Rajendran S, Qin J, Yola ML, Atar N, Gracia F. Nanosized Fe3O4 incorporated on a TiO2 surface for the enhanced photocatalytic degradation of organic pollutants. J Mol Liq. 2019;287:110967. doi: 10.1016/j.molliq.2019.110967. [DOI] [Google Scholar]
- 14.Channei D, Inceesungvorn B, Wetchakun N, Phanichphant S. Synthesis of Fe3O4/SiO2/CeO2 core-shell magnetic and their application as photocatalyst. J Nanosci Nanotechnol. 2014;14:7756–7762. doi: 10.1166/jnn.2014.9427. [DOI] [PubMed] [Google Scholar]
- 15.Zhang H, He X, Zhao W, Peng Y, Sun D, Li H, Wang X. Preparation of Fe3O4/TiO2 magnetic mesoporous composites for photocatalytic degradation of organic pollutants. Water Sci Technol. 2017;75:1523–1528. doi: 10.2166/wst.2017.002. [DOI] [PubMed] [Google Scholar]
- 16.Bouiahya K, Oulguidoum A, Laghzizil A, Shalabi M, Nunzi JM, Masse S. Hydrophobic chemical surface functionalization of hydroxyapatite nanoparticles for naphthalene removal. Colloid Surf A. 2020;595:124706. doi: 10.1016/j.colsurfa.2020.124706. [DOI] [Google Scholar]
- 17.Bouyarmane H, El Hanbali I, El Karbane M, Rami A, Saoiabi A, Saoiabi S, Masse S, Coradin T, Laghzizil A. Parameters influencing ciprofloxacin, ofloxacin, amoxicillin and sulfamethoxazole retention by natural and converted calcium phosphates. J Hazard Mater. 2015;291:38–44. doi: 10.1016/j.jhazmat.2015.02.049. [DOI] [PubMed] [Google Scholar]
- 18.Mushtaq A, Zhao R, Luo D, Dempsey E, Wang X, Iqbal MZ, Kong X. Magnetic hydroxyapatite nanocomposites: the advances from synthesis to biomedical applications. Mater Des. 2021;197:109269. doi: 10.1016/j.matdes.2020.109269. [DOI] [Google Scholar]
- 19.Kim HH, Seo H, Dae-Lee K, Oh J, Mondal S, Manivasagan P, Bharathiraja S, Moorthy MS. Magnetic hydroxyapatite: a promising multifunctional platform for nanomedicine application. Int J Nanomedicine. 2017;12:8389–410. doi: 10.2147/IJN.S147355. [DOI] [PMC free article] [PubMed] [Google Scholar]
- 20.Ansar EB, Ajeesh M, Yokogawa Y, Wunderlich W, Varma H. Synthesis and characterization of Iron Oxide embedded Hydroxyapatite Bioceramics. J Am Ceram Soc. 2012;95:2695–2699. doi: 10.1111/j.1551-2916.2011.05033.x. [DOI] [Google Scholar]
- 21.Yang ZP, Gong XY, Zhang CJ. Recyclable Fe3O4/hydroxyapatite composite nanoparticles for photocatalytic applications. Chem Eng J. 2010;165:117–121. doi: 10.1016/j.cej.2010.09.001. [DOI] [Google Scholar]
- 22.Valizadeh S, Rasoulifard MH, Dorraji MS. Modified Fe3O4- hydroxyapatite nanocomposites as heterogeneous catalysts in three UV, Vis and Fenton like degradation systems. Appl Surf Sci. 2014;319:358–66. doi: 10.1016/j.apsusc.2014.07.139. [DOI] [Google Scholar]
- 23.Hou P, Shi C, Wu L, Hou X. Chitosan/hydroxyapatite/Fe3O4 magnetic composite for metal-complex dye AY220 removal: recyclable metal-promoted Fenton-like degradation. Microchem J. 2016;128:218–225. doi: 10.1016/j.microc.2016.04.022. [DOI] [Google Scholar]
- 24.Fan L, Liu H, Gao C, Zhu P. Facile synthesis and characterization of magnetic hydroxyapatite/Fe3O4 microspheres. Mater Lett. 2022;313:131648. doi: 10.1016/j.matlet.2022.13164. [DOI] [Google Scholar]
- 25.El Asri S, Laghzizil A, Coradin T, Saoiabi A, Alaoui A, M’hamedi R. Conversion of natural phosphate rock into mesoporous hydroxyapatite for heavy metals removal from aqueous solution. Colloid Surf A. 2010;362:33–8. doi: 10.1016/j.colsurfa.2010.03.036. [DOI] [Google Scholar]
- 26.El Bekkali C, Labrag J, Oulguidoum A, Chamkhi I, Laghzizil A, Nunzi JM, Robert D, Aurag J. Porous ZnO/hydroxyapatite nanomaterials with effective photocatalytic and antibacterial activities for the degradation of antibiotics. Nanotechnol Environ Eng. 2021;7:333–341. doi: 10.1007/s41204-021-00172-7. [DOI] [Google Scholar]
- 27.Bouyarmane H, El Bekkali C, Labrag J, Es-saidi I, Bouhnik O, Abdelmoumen H, Laghzizil A, Nunzi JM, Robert D. Photocatalytic degradation of emerging antibiotic pollutants in waters by TiO2/Hydroxyapatite nanocomposite materials. Surf Interfaces. 2021;24:101155. doi: 10.1016/j.surfin.2021.101155. [DOI] [Google Scholar]
- 28.Singh H, Rajput J. Novel perovskite nanocatalyst (BiFeO3) for the photodegradation of rhodamine B/tartrazine and swift reduction of nitro compounds. J Iran Chem Soc. 2019;16:2409–32. doi: 10.1007/s13738-019-01710-6. [DOI] [Google Scholar]
- 29.Arora P, Fermah A, Rajput JK, Singh H, Badhan J. Efficient solar light-driven degradation of Congo red with novel Cu-loaded Fe3O4@TiO2 nanoparticles. Environ Sci Pollut Res. 2017;24:19546–19560. doi: 10.1007/s11356-017-9571-7. [DOI] [PubMed] [Google Scholar]
- 30.Singh H, Rajput JK, Govil G, Arora P, Badhan J. Dual functional novel catalytic Cu1 – xZrxFe2O4 (x = 0, 0.5, 1) nanoparticles for synthesis of polysubstituted pyridines and sunlight-driven degradation of methylene blue. Appl Organomet Chem. 2018;10:e4514. doi: 10.1002/aoc.4514. [DOI] [Google Scholar]
- 31.Bekkali E, Bouyarmane C, El Karbane H, Masse M, Saoiabi S, Coradin A, Laghzizil T. Zinc oxide-hydroxyapatite nanocomposite photocatalysts for the degradation of ciprofloxacin and ofloxacin antibiotics. Colloid Surf A. 2018;539:364–70. doi: 10.1016/j.colsurfa.2017.12.051. [DOI] [Google Scholar]
Associated Data
This section collects any data citations, data availability statements, or supplementary materials included in this article.
Data Availability Statement
Not applicable.